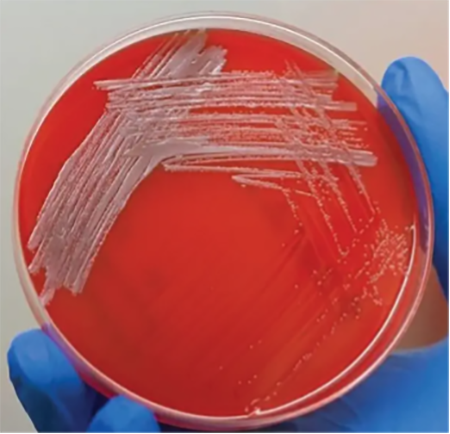

August 2024 Case
Clinical History
A young adult, with no known past medical history presented to the ED with fever, abdominal pain, and malaise who was found to have significantly elevated liver enzymes and splenic infarcts. Patient was previously healthy with no history of liver disease. Additional history includes recent travel to Mexico and consumption of 6-12 alcoholic beverages per week. In the ED, patient was found to have splenic infarcts with hepatosplenomegaly on CT and LFTs >6000. Additionally, had fevers and tachycardia to the 130s. Due to worsening symptoms and OLT evaluation, patient was eventually transferred to Cedars-Sinai.
An initial hepatitis panel was negative and autoimmune workup was sent out. Additionally, a liver biopsy was performed. Patient again had fevers up to 39.4 and tachycardia in the 130s and was started on empiric antibiotics. Two sets of blood cultures were collected and sent to microbiology for testing.

Fig. 1: Gram stain showing the faintly staining gram-negative coccobacilli Brucella melitensis.
Fig 2: 5% sheep's blood agar plate growing Brucella melitensis
Blood culture:
The aerobic bottle from both blood cultures grew a gram-negative coccobacillus after 2 days of incubation (fig. 1). The organism was catalase positive and oxidase positive and grew best on 5% sheep's blood agar at 35*C in a CO2 enriched environment (fig. 2). It was identified by MALDI-TOF as Brucella melitensis. The sample was submitted to Los Angeles Public Health Department for confirmatory testing.
Clinical course:
The patient was started on empiric vancomycin and piperacillin-tazobactam which was later switched to doxycycline and IV gentamicin after identification of Brucella bacteremia. Symptoms of sepsis gradually improved. The liver biopsy revealed acute liver injury with active cholestatic hepatitic pattern, which also began resolving with supportive care and no longer being considered for OLT. Patient was then transferred back to the original hospital for continuity of care.
Discussion
Brucellosis is a zoonotic infection caused by the bacterial genus Brucella. The bacteria are transmitted from animals to humans by ingestion through infected food products, direct contact with an infected animal, or inhalation of aerosols. The disease is an old one that has been known by various names, including Mediterranean fever, Malta fever, gastric remittent fever, and undulant fever. Humans are accidental hosts, but brucellosis continues to be a major public health concern worldwide and is the most common zoonotic infection.
Brucellae are small gram-negative nonmotile coccobacilli which can be isolated as part of the normal flora of the genitourinary tract of a variety of wild and domestic animals including cows, goats, sheep, pigs, and dogs. The organism is strictly aerobic, nonencapsulated, and catalase and oxidase positive; it does not ferment carbohydrates and has variable urease activity. Based on DNA homology, it has been demonstrated that all six members of the genus are, in fact, serovars of a single species of which four, namely, Brucella abortus, B. suis, B. canis, and especially B. melitensis are able to cause human infections.
Definitive diagnosis of brucellosis is based on culture, serologic techniques, or both. Clinically, identification to the genus level is sufficient to warrant initiation of therapy. The particular Brucella species involved does not affect the choice of therapeutic agents; however, speciation is necessary for epidemiologic surveillance and requires more detailed biochemical, metabolic, and immunologic testing.
References
- Freddi L, de la Garza-García JA, Al Dahouk S, Occhialini A, Köhler S. 2023. Brucella spp. are facultative anaerobic bacteria under denitrifying conditions. Microbiol Spectr 11:e02767-23. doi:10.1128/spectrum.02767-23
- Yagupsky P. Detection of Brucellae in blood cultures. J Clin Microbiol. 1999 Nov;37(11):3437-42. doi: 10.1128/JCM.37.11.3437-3442.1999. PMID: 10523530; PMCID: PMC85661.